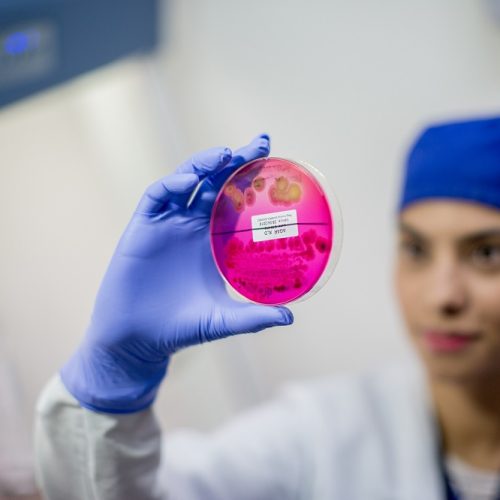

Laboratorios de diagnóstico veterinario del ICMT recibieron registro ICA
Laboratorios de diagnóstico veterinario del ICMT recibieron registro ICA
-
date_range
Fecha publicación: 28 de julio 2021
Un nuevo logro destaca la labor desempeñada por el Instituto Colombiano de Medicina Tropical (ICMT) de la Universidad CES al ser otorgado el registro del Instituto Colombiano Agropecuario (ICA) a sus laboratorios de diagnóstico veterinario.
Por medio de la Resolución 097551 de mayo de 2021, el ICA otorgó el registro a los laboratorios de diagnóstico veterinario ubicados en las sedes Envigado y Sabaneta de la Universidad CES en Antioquia, para los próximos 10 años.
“Muchos laboratorios en clínicas privadas no tienen ningún tipo de aval o reconocimiento por una entidad que regule. Nosotros por el hecho de hacerlas bien tomamos la decisión que los laboratorios estén avalados, acreditados por las entidades competentes”, expresó Luis Ernesto López Rojas, director del ICMT.
El registro fue otorgado para las pruebas de bacteriología, parasitología y serología para el Laboratorio Diagnóstico Veterinario ICMT Envigado y de biología molecular para el Laboratorio Diagnóstico Veterinario ICMT Sabaneta.
Actualmente, el instituto adelanta actividades de autoevaluación para procesos habilitados en servicios de salud de la IPS CES Sabaneta y la sede Apartadó, y la autoevaluación del Laboratorio de Microbiología industrial para acreditación por parte del Organismo Nacional de Acreditación de Colombia (ONAC).
El ICMT es reconocido como un centro de investigación por Colciencias. Cuenta en su portafolio de servicios e infraestructura con una planta de producción de medios de cultivo y colorantes que clasifican en el Invima como reactivos de diagnóstico in vitro. También tiene la autorización sanitaria por parte del Invima para fabricar y vender los productos. La planta es de nivel 1 y están gestionando para que sea reconocida en nivel 3, para producir reactivos en grado molecular.